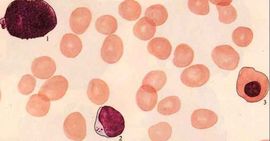
急性再生障礙性貧血 急性再生障礙性貧血

概要
1、感染:以呼吸道感染最為常見,其他有消化道、泌尿生殖道及皮膚感染等。感染的菌種以革蘭氏陰性桿菌、 金黃色葡萄球菌和真菌為主,常合併敗血症。
2、貧血:
3、出血:
臨床實驗室檢查
(1)血象
1、 白細胞及分類:白細胞多<2×10^9/L; 中性粒細胞≤0.05×10^9/L,淋巴細胞比例明顯增高。
2、血紅蛋白及紅細胞:為正色素性正細胞貧血。患者經 大量輸血雖血紅蛋白有所提高,但維持時間 短,很快下降。
3、 網織紅細胞:網織紅細胞在外周血液中的數值可反映骨髓紅細胞的生成功能,對再障的診斷和觀察治療反應均有重要意義。急性型 網織紅細胞低至0,多數病例在0.5%以下。
4、 血小板:多數在15×10^9/L以下。
(2)骨髓象
①多部位增生減低或重度減低,粒、 紅細胞系明顯減少,淋巴細胞相對增多。
②粒細胞系減少以成熟粒細胞為主。
③紅細胞系統減少,比例下降,以晚幼紅細胞-“炭核”為主,成熟紅細胞形態多無明顯變化。
④ 漿細胞、組織嗜鹼細胞、組織細胞等比例增多。
⑤絕大多數患者骨髓找不到巨核細胞。
診斷標準
國內急性再生障礙性貧血(亦稱SAA-I型)的診斷標準:
⑴臨床表現:發病急,貧血呈進行性加劇;常伴嚴重感染,內臟出血。
⑵ 血象:除 血紅蛋白下降較快外,須具備以下駐項中之兩項:
①網織紅細胞小於1%, 絕對值小於15×10^9/L;
②白細胞明顯減少、 中性粒細胞絕對值小於0.5×10^9/L;
③血小板小於20×10^9/L。
⑶骨髓象:
①多部位增生減低,三系 造血細胞明顯減少,非造血細胞增多。如增生活躍須有淋巴細胞增多;
② 骨髓小粒 中非 造血細胞及脂肪細胞增多。
治療方案及預防
免疫抑制治療
1、 抗淋巴細胞球蛋白(ALG)、 抗胸腺細胞球蛋白(ATG):本品具有針對免疫活性T抑制 細胞介導免疫的功能,它們能誘發T細胞增殖,使造血恢復。
2、 環孢菌素A(CSA):是一種Ts細胞Tc 細胞克隆的殺傷劑,糾正再障患者的免疫紊亂,促使重症再障的骨髓 造血功能恢復。
骨髓移植(BMT)
用骨髓移植治療 再生障礙性貧血,在國外已取得許多經驗,由於骨髓移植不易找到HLA組織配型相近的供髓者,而且耗費大量人力、物力,故應嚴格選擇適應證,關於適應證,有如下看法:重症再障(老年人除外),粒細胞在0.5×10^9/L以下,血小板在20×10^9/L以下,骨髓內 淋巴細胞在75%以上;最好在確診後起3個月以內進行;年齡在20歲以下;移植前輸血次數少者(最好未輸過血);HLA配型相同。
預防
1.避免感染,尤其是感冒症狀,臨床上將病毒感染也作為診斷再生障礙性貧血的病因之一,比較常見的就是肝炎病毒,監床發現再生障礙性貧血多發於非甲非B型肝炎,而與A型肝炎無關。有些再生障礙性貧血患者發病前有感冒史,說明部分再生障礙貧血可繼發於普通感冒之後。
2.用藥上要科學,一定要嚴格按照相關的用藥事項進藥,切不可自行增減藥量,最好是諮詢相關的專家輔導用藥,必要時可觀察血象變化,以便及時停藥。避免接觸苯等有害化學物質。有超量飲用糖精導致再生障礙性貧血的報導,故宜少食糖精。患營養性貧血,應積極治療,以免遷延不愈發展成再生障礙性貧血。
3.避免長期接觸高輻射物質,因為人體長期處於輻射量高的環境中,就會導致體內全血紅細胞減少,進而誘發血液病,所以長期處於放射工作的朋友,必須嚴格遵守操作制度,加強防護,這樣可減少再生障礙性貧血發生的幾率,避免過多照射發生。化學物質尤其是藥物,是導致再生障礙性貧血的最常見因素,所以必須注意合理用藥。
預後與轉歸
急性再生障礙性貧血的是一組發病急、進展快的骨髓衰竭性疾病,常伴內臟出血、嚴重感染,常危及生命,預後不良;在治療上予以清熱涼血解毒中藥,積極配合西醫學的成分血輸注、廣譜 抗生素、丙種球蛋的、造血刺激因子等支持療法,或可配合免疫抑制劑治療,可挽救相當一部分患者生命。
飲食療法
1、補髓湯:鱉1隻,豬骨髓200克,生薑、蔥、胡椒粉、味素各適量。將鱉用開水燙死,揭去鱉甲,去 內臟和頭爪;將豬骨髓洗淨待用。將鱉肉放入鋁鍋內,加生薑、蔥和胡椒粉,用武火燒沸,再用文火將鱉魚煮熟,然後放入豬骨髓,煮熟加味素即成。吃肉,喝湯,亦可佐餐食用。 滋陰 補腎,填精補髓。適用於 腎陰虛、頭昏目眩、腰膝酸痛及再生障礙性貧血等症。
2、蔥燒海參:水發 海參500克,清湯250克,油菜心2棵,料酒9克,濕玉米澱粉9克,熟豬油45克,蔥120克,醬油、味素、食鹽各適量。將水發海參洗淨,用開水氽一下,用熟豬油將蔥段炸黃,製成蔥油;海參下鍋,加入清湯100克和醬油、味素、食鹽、料酒,用微火燉爛。將海參撈出,放入大盤內,原湯不用。將菜心碼放在海參上。鍋內放清湯150克,再加醬油、味素、食鹽、料酒等調料,用濕玉米澱粉勾芡,澆在海參、菜心上,淋上蔥油即成。佐餐食。滋肺 補腎,益精壯陽。適用於 肺陰虛所致的乾咳、咯血; 腎陰虛所致的陽痿、 遺精; 血虛所致的再生障礙性貧血及糖尿病等。
3、海參散:海參250克切片,焙乾研末。日服3次,每服9克。適用於再生障礙性貧血之頭暈、腰酸、足軟者。
4、花生衣湯:花生衣10克,水煎服。日服3次。適用於再生障礙性貧血之出血者。
5、二味糯米粥:薺菜花、 血糯米(或粳米)各50克,藕粉30克(或鮮藕150克),加水1000毫升,文火煨稠粥。每日早、中、晚三次分服,宜涼服。用治再生障礙性貧血之各種出血者。
護理要點
急性再障起病急,病情發展快,死亡率高。優良的護理能減輕病人的痛苦,且能較好的預防併發症的發生,對搶救病人,延長 急性再障患者生命均有重要作用,以下是急性再障的護理措施:
1、在急性期,病人嚴格臥床休息。在病情穩定後可適當活動。
2、注意飲食的選擇:宜選擇高蛋白、富含維生素、易消化的食品。高熱或消化道出血病人應選擇無渣半流或流質飲食,如稀飯、麵條等。消化道大出血時應禁食。
3、注意做好心理護理:因起病急、病情重,病人的精神負擔重,做好心理護理至關重要。病人親屬及醫護人員要關心體貼病人,鼓勵病人樹立戰勝疾病的信心。做好仔細耐心的解釋工作,使病人主動配合治療及 護理工作。
4、注意保持口腔清潔:囑病人飯後漱口,多飲水,必要時用含 抗生素的漱口液。若口腔內有潰瘍或炎症可局部塗抹藥膏。
5、搞好病人的清潔衛生工作:因出汗、發熱、皮膚可並發癤腫,應注意皮膚的清潔衛生,勤給病人洗澡,更換內衣。長期臥床病人應定時翻身,以防止 褥瘡發生。